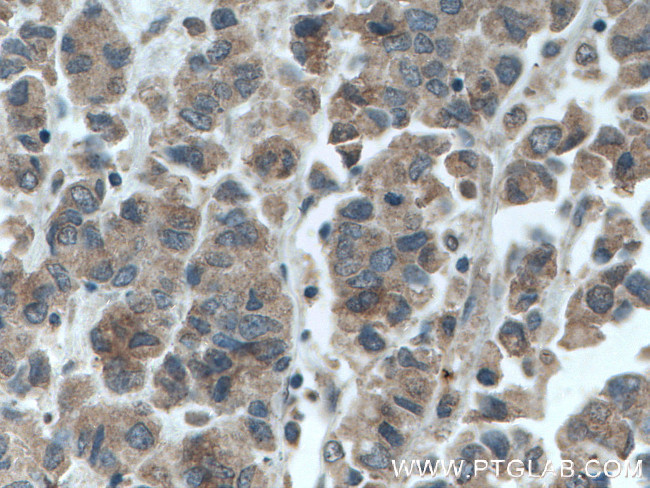
GRASP65/GORASP1 Antibody in Immunohistochemistry (Paraffin) (IHC (P))

Search
Proteintech
GRASP65/GORASP1 Monoclonal Antibody (1B2C10)
{{$productOrderCtrl.translations['antibody.pdp.commerceCard.promotion.promotions']}}
{{$productOrderCtrl.translations['antibody.pdp.commerceCard.promotion.viewpromo']}}
{{$productOrderCtrl.translations['antibody.pdp.commerceCard.promotion.promocode']}}: {{promo.promoCode}} {{promo.promoTitle}} {{promo.promoDescription}}. {{$productOrderCtrl.translations['antibody.pdp.commerceCard.promotion.learnmore']}}
产品信息
66651-1-IG
种属反应
宿主/亚型
分类
类型
克隆号
抗原
偶联物
形式
浓度
纯化类型
保存液
内含物
保存条件
运输条件
产品详细信息
Immunogen sequence: MGLGVSAEQ PAGGAEGFHL HGVQENSPAQ QAGLEPYFDF IITIGHSRLN KENDTLKALL KANVEKPVKL EVFNMKTMRV REVEVVPSNM WGGQGLLGAS VRFCSFRRAS EQVWHVLDVE PSSPAALAGL RPYTDYVVGS DQILQESEDF FTLIESHEGK PLKLMVYNSK SDSCRESGMW HWLWVSTPDP NSAPQLPQEA TWHPTTFCST TWCPTT (1-215 aa encoded by B C008928)
靶标信息
Grasp65 is a structural protein of the golgi apparatus. It has been implicated in the stacking of golgi cisternae. Grasp65 is shown to have the properties to bind surfaces together in a mitotically regulated matter.
仅用于科研。不用于诊断过程。未经明确授权不得转售。
生物信息学
蛋白别名: Golgi peripheral membrane protein p65; Golgi phosphoprotein 5; Golgi reassembly and stacking protein 1; golgi reassembly stacking protein 1, 65kDa; Golgi reassembly-stacking protein 1; Golgi reassembly-stacking protein of 65 kDa; GOLPH5; GRASP65
基因别名: 5430411C10Rik; GOLPH5; GORASP1; GRASP65; P65
UniProt ID: (Human) Q9BQQ3, (Mouse) Q91X51
Entrez Gene ID: (Human) 64689, (Rat) 56082, (Mouse) 74498